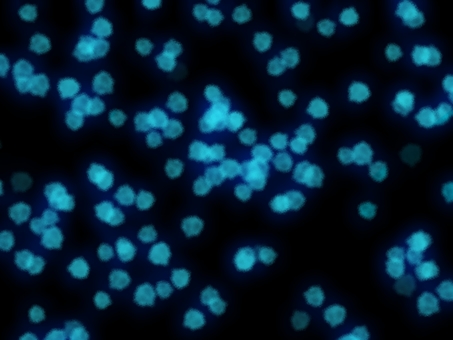
パーティクル背景　透過あり 背景,キラキラ,玉ボケ,パーティクル,エフェクト,デコレーション,光沢,豪華,エネルギー,煌めきのイラスト素材

検索フィルター
全1,752件中 1 - 70件
たくさんのイラストレーターの方から投稿された「先進的」に関連したフリーイラスト素材・画像を掲載しております。気に入った「先進的」に関連したフリーイラスト素材・画像が見つかったら、イラストの画像をクリックして、無料ダウンロードページへお進み下さい。イラストダウンロードページには、イラストレーターのプロフィールページへのリンクもあり、直接オリジナルイラスト作成のお仕事を依頼することもできますよ。
キーボードの左右の矢印キーで
ページを移動することができます。
ページを移動することができます。
前のページ
次のページ
プレミアム会員に参加して、広告非表示プランを選択してください。
ブックマークするにはログインしてください。
ファン登録するにはログインしてください。
プレミアム会員になると、まとめてダウンロードをご利用いただけます。
恐れ入ります。無料会員様が一日にダウンロードできるEPS・AIデータの数を超えております。プレミアム会員になると無制限でダウンロードが可能です。
商品化ライセンスの購入は、プレミアム会員様限定です。
すでに商品化ライセンスを購入しています。
マイページでご確認ください。
マイページでご確認ください。
無料で高品質なイラストをダウンロードできます!加工や商用利用もOK!
無料ダウンロード会員登録はこちら
商品化ライセンスの購入は、プレミアム会員様限定です。
プレミアム会員に参加して、まとめてダウンロードしよう!